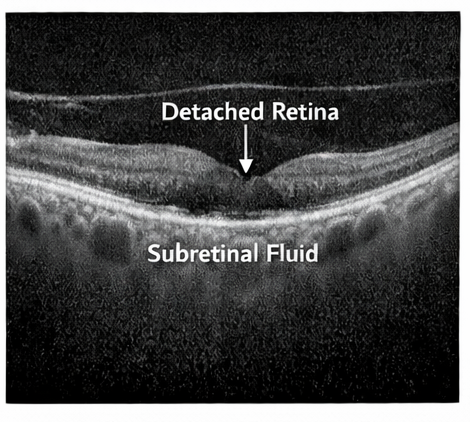

Retinal detachment is a vision-threatening ophthalmic emergency characterized by the separation of the neurosensory retina from the underlying retinal pigment epithelium. The condition can lead to permanent visual impairment if not diagnosed and treated promptly. Retinal detachment is commonly classified into rhegmatogenous, tractional, and exudative types, with rhegmatogenous retinal detachment being the most frequent. Patients typically present with symptoms such as flashes of light, floaters, visual field defects, or sudden decrease in vision. Diagnosis relies on clinical examination and imaging modalities such as indirect ophthalmoscopy and ocular ultrasonography. Timely surgical intervention significantly improves visual prognosis. This case report describes a middle-aged patient presenting with sudden visual disturbances who was diagnosed with rhegmatogenous retinal detachment and successfully managed with surgical repair.
Retinal detachment is a serious ocular condition in which the neurosensory retina separates from the retinal pigment epithelium, disrupting photoreceptor function and potentially leading to irreversible vision loss. The most common form, rhegmatogenous retinal detachment, occurs when a retinal break allows vitreous fluid to accumulate beneath the retina. Other forms include tractional retinal detachment, usually associated with proliferative diabetic retinopathy, and exudative retinal detachment caused by inflammatory or vascular disorders.
Several risk factors are associated with retinal detachment, including high myopia, trauma, previous ocular surgery, lattice degeneration, and aging-related vitreous changes. Early symptoms often include photopsia (flashes of light), floaters, or a shadow or curtain-like visual field defect.
Prompt diagnosis and management are crucial because untreated retinal detachment may lead to permanent visual loss. This report presents a case of rhegmatogenous retinal detachment diagnosed through ophthalmic examination and imaging.
Patient History
A 52-year-old male presented to the ophthalmology outpatient department with complaints of sudden onset flashes of light and multiple floaters in the right eye for two days. The patient also reported progressive blurring of vision and a shadow in the peripheral visual field.
There was no history of ocular trauma. However, the patient had a history of high myopia and had undergone cataract surgery in the same eye two years earlier.

The patient denied eye pain, redness, or discharge. His medical history was otherwise unremarkable.
On general examination, the patient was stable with normal vital signs.
Ophthalmic examination findings:
• Visual acuity
Right eye: 6/36
Left eye: 6/6
• Intraocular pressure
Right eye: 14 mmHg
Left eye: 15 mmHg
Anterior segment examination of both eyes was unremarkable.
Fundoscopic examination of the right eye revealed an elevated retina with a retinal tear in the superotemporal quadrant and surrounding subretinal fluid. The macula appeared partially detached.
The left eye showed mild myopic changes but no evidence of retinal pathology.
Differential Diagnosis
Based on symptoms and clinical findings, the following conditions were considered:
• Rhegmatogenous retinal detachment
• Posterior vitreous detachment
• Vitreous hemorrhage
• Retinal tear without detachment
Further diagnostic evaluation was performed to confirm the diagnosis.
Optical Coherence Tomography (OCT)
OCT imaging demonstrated separation of the neurosensory retina from the retinal pigment epithelium in the macular region of the right eye.

Ocular Ultrasonography
B-scan ultrasonography confirmed the presence of retinal detachment with a mobile detached retina and associated vitreous changes.
No intraocular mass or hemorrhage was detected.
Based on the clinical findings and imaging results, a diagnosis of rhegmatogenous retinal detachment of the right eye was established.
Clinical Management
The patient was counseled regarding the need for urgent surgical intervention to prevent further visual deterioration.
The following treatment options were discussed:
• Pneumatic retinopexy
• Scleral buckle surgery
• Pars plana vitrectomy
Considering the location of the retinal tear and partial macular involvement, pars plana vitrectomy with gas tamponade was recommended.

Surgical Findings
During surgery, a retinal break was identified in the superotemporal quadrant. Vitrectomy was performed to remove vitreous traction, followed by laser photocoagulation around the retinal tear.
An intraocular gas bubble was injected to support retinal reattachment.
The postoperative period was uneventful.
At one-month follow-up:
• The retina remained fully attached.
• Visual acuity improved to 6/18 in the affected eye.
At three months, further improvement in vision was noted, and the patient reported resolution of visual field defects.

Retinal detachment is a vision-threatening condition that requires prompt diagnosis and treatment. Rhegmatogenous retinal detachment accounts for the majority of cases and typically results from retinal tears that allow fluid to accumulate beneath the retina.
Posterior vitreous detachment associated with aging or myopia is a common predisposing factor. Other risk factors include previous ocular surgery, trauma, and retinal degenerative changes.
The classic symptoms of retinal detachment include photopsia, floaters, and a curtain-like visual field defect. Early detection is essential because visual outcomes are significantly better when the macula remains attached.
Fundoscopic examination remains the primary diagnostic method, while imaging modalities such as optical coherence tomography and B-scan ultrasonography provide valuable confirmation, especially when media opacity limits visualization.
Treatment options depend on the extent and location of detachment. Surgical techniques such as scleral buckling, pneumatic retinopexy, and pars plana vitrectomy have high success rates in restoring retinal attachment and preserving vision.
Retinal detachment is an ophthalmic emergency that can lead to permanent vision loss if not diagnosed and treated promptly. Early recognition of warning symptoms such as sudden flashes of light, new-onset floaters, blurred vision, or the appearance of a curtain-like shadow over the visual field is essential for early clinical suspicion. These symptoms often indicate traction or separation of the neurosensory retina from the underlying retinal pigment epithelium. A prompt and thorough ophthalmic evaluation, including dilated fundus examination and imaging modalities such as optical coherence tomography (OCT) or B-scan ultrasonography, is critical for confirming the diagnosis and assessing the extent and type of detachment.
Timely intervention significantly improves the chances of restoring vision and preventing irreversible retinal damage. Treatment options depend on the type, location, and severity of the detachment and may include procedures such as pneumatic retinopexy, scleral buckle surgery, or pars plana vitrectomy. Advances in vitreoretinal surgical techniques and early diagnosis have greatly improved patient outcomes in recent years. With appropriate and timely surgical management, many patients achieve successful retinal reattachment, stabilization of retinal structure, and meaningful recovery or preservation of visual function.
Read more such content on @ Hidoc Dr | Medical Learning App for Doctors
1.
Why breast cancer survivors don't take their medicine, and what can be done about it.
2.
The Higher the Disability Burden From Disease, the Higher the Suicide Risk
3.
FDA Approves New Drug Combo for RR Multiple Myeloma
4.
Big Gain in PFS With Metastasis-Directed RT for Oligometastatic Pancreatic Cancer
5.
Adding Chemo to Osimertinib Doubles PFS in Advanced NSCLC
1.
Revolutionizing Thyroid Cancer: Advances in Molecular Genetics and Personalized Treatment Approaches
2.
HCC Codes in Oncology: Care Optimization in Plexiform Neurofibroma Management
3.
Understanding Mantle Cell Lymphoma Prognosis.
4.
Unveiling the Hidden Dangers of Hand Cancer: How to Protect Yourself
5.
Understanding Evans Syndrome: Causes, Symptoms, and Treatment Options
1.
International Lung Cancer Congress®
2.
Genito-Urinary Oncology Summit 2026
3.
Future NRG Oncology Meeting
4.
ISMB 2026 (Intelligent Systems for Molecular Biology)
5.
Annual International Congress on the Future of Breast Cancer East
1.
Unmet Needs in ALK Positive NSCLC- The Challenges in the Current Care
2.
From Relapse to Remission: Mapping the Treatment Journey in Adult R/R-Cell ALL - Part 2
3.
First-Line Maintenance Therapy for Metastatic Urothelial Carcinoma: Bridging Clinical Practice and Trials
4.
Navigating the Complexities of Ph Negative ALL - Part VIII
5.
Navigating the Complexities of Ph Negative ALL - Part XIV
© Copyright 2026 Hidoc Dr. Inc.
Terms & Conditions - LLP | Inc. | Privacy Policy - LLP | Inc. | Account Deactivation